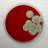

Synopsis of Social media discussions
This collection of discussions consistently supports the study’s conclusion that microbiome diversity is vital for pathogen resistance, with examples such as mentions of 'nutrient consumption' and 'community protection.' The tone ranges from straightforward agreement to more detailed references to mechanisms, showing both high consensus and meaningful engagement on the research’s implications for health and microbiology.
Agreement
Strong agreementThe majority of discussions strongly support the findings, emphasizing how microbiome diversity plays a crucial role in protecting against pathogens through nutrient competition.
Interest
High level of interestMany posts express high curiosity and focus on the significance of microbiome diversity, highlighting its biological importance and potential health implications.
Engagement
Moderate level of engagementWhile most comments acknowledge the research, some posts delve into mechanisms like nutrient blocking and community functions, indicating a moderate level of detailed engagement.
Impact
High level of impactThe repeated emphasis on microbiome diversity’s role in resisting pathogens suggests these discussions recognize the study’s broad significance for understanding infectious resistance and therapeutic strategies.
Social Mentions
YouTube
2 Videos
Bluesky
6 Posts
12 Posts
178 Posts
7 Posts
Blogs
1 Articles
News
15 Articles
2 Posts
Metrics
Video Views
525
Total Likes
724
Extended Reach
5,129,771
Social Features
223
Timeline: Posts about article
Top Social Media Posts
Posts referencing the article

Probiotics and Microbes: Enhancing Gut Health and Disease Prevention
Good bacteria act as tiny bodyguards by fighting harmful pathogens, boosting immunity, and strengthening barriers. Learn how probiotics work and their applications in health and food industries.

Essential Foods for Improving Gut Health and Digestion
If you're dealing with digestive issues, this video is here to help. We'll explore the significant health benefits of fermented foods and their role in enhancing the gut microbiome, alongside fiber-rich options to promote better digestion. Subscribe for more nutrition insights!
-

Microbiome diversity protects against pathogens by nutrient blocking | Science https://t.co/oJLAYt05FE
view full postApril 17, 2025
-

RafaelCustodio
@RafaelC68142023 (Twitter)RT @EvolvedBiofilm: Kathrin finishes on published works from Volholt and Foster labs on how microbiome diversity contributes to function -o…
view full postJune 19, 2024
1
-

Akos T. Kovacs
@EvolvedBiofilm (Twitter)Kathrin finishes on published works from Volholt and Foster labs on how microbiome diversity contributes to function -on plant leaves: https://t.co/VhkKxeBN2h -innthe gut: https://t.co/BWUqGGrbBW #PMS2024
view full postJune 19, 2024
2
1
-

Willem van Schaik
@wvschaik.bsky.social (Bluesky)Excellent first talk by Frances Spragge (Kevin Foster lab) on how microbiome diversity protects against pathogens by nutrient blocking pubmed.ncbi.nlm.nih.gov/38096285/
view full postMay 22, 2024
2
2
-

Gustavo Ybazeta
@ybazetag (Twitter)RT @ErikBakkeren: Online @ScienceMagazine co-lead with @francesspragge1! We looked at why microbiome diversity protects against pathogens.…
view full postMay 3, 2024
80
-

Dr Dimitar Georgiev
@dimitar_dr (Twitter)да излезем малко от политиката и да отворим едно интересно неделно четиво - как чревният ни микробиом ни пази от инфекции Microbiome diversity protects against pathogens by nutrient blocking | Science https://t.co/pQcC3pGpy2
view full postMarch 31, 2024
7
-

Marta Noya (Martouta)
@MartoutaTech (Twitter)RT @katiewr31413491: Microbiome of ASD/ GI kids severely lacking in diversity. ⭐️⭐️⭐️⭐️⭐️⭐️ Microbiome diversity protects against pathogens…
view full postMarch 19, 2024
7
-

Ignacio F. Alberti
@IgnacioFALBERTI (Twitter)#Microbiome diversity protects against #pathogens by nutrient blocking. https://t.co/4K5AYywlMP @ScienceMagazine Frances Spragge, @ErikBakkeren, @martintjah, Elizete Araujo, Claire Pearson, Xuedan Wang, Louise Pankhurst, @CunrathOlivier, Kevin Foster (@UniofOxford) https://t.co/ikd57rbgmP
view full postMarch 18, 2024
-

Dr Paris Tavakoli
@TavakoliParis (Twitter)RT @GMFHx: Diversity is a hallmark of a healthy microbiome. The rationale is that accumulating evidence suggests microbiome diversity prot…
view full postMarch 16, 2024
4
-

Barbara C. Hickman
@_bhickman (Twitter)RT @katiewr31413491: Microbiome of ASD/ GI kids severely lacking in diversity. ⭐️⭐️⭐️⭐️⭐️⭐️ Microbiome diversity protects against pathogens…
view full postMarch 15, 2024
7
-

latetobones
@danaotr (Twitter)RT @katiewr31413491: Microbiome of ASD/ GI kids severely lacking in diversity. ⭐️⭐️⭐️⭐️⭐️⭐️ Microbiome diversity protects against pathogens…
view full postMarch 15, 2024
7
-

John Stone
@JohnStone32 (Twitter)RT @katiewr31413491: Microbiome of ASD/ GI kids severely lacking in diversity. ⭐️⭐️⭐️⭐️⭐️⭐️ Microbiome diversity protects against pathogens…
view full postMarch 15, 2024
7
-

Age of Autism
@AgeofAutism (Twitter)RT @katiewr31413491: Microbiome of ASD/ GI kids severely lacking in diversity. ⭐️⭐️⭐️⭐️⭐️⭐️ Microbiome diversity protects against pathogens…
view full postMarch 15, 2024
7
-

Szyzygy
@Szyzygy2 (Twitter)RT @katiewr31413491: Microbiome of ASD/ GI kids severely lacking in diversity. ⭐️⭐️⭐️⭐️⭐️⭐️ Microbiome diversity protects against pathogens…
view full postMarch 15, 2024
7
-

Thinking Autism
@TweetingAutism (Twitter)RT @katiewr31413491: Microbiome of ASD/ GI kids severely lacking in diversity. ⭐️⭐️⭐️⭐️⭐️⭐️ Microbiome diversity protects against pathogens…
view full postMarch 15, 2024
7
-

katie wright
@katiewr31413491 (Twitter)Microbiome of ASD/ GI kids severely lacking in diversity. ⭐️⭐️⭐️⭐️⭐️⭐️ Microbiome diversity protects against pathogens by nutrient blocking | Science https://t.co/VWRvYJ5oW7
view full postMarch 15, 2024
12
7
-

Makala Moore
@MakalaMoore8 (Twitter)RT @GMFHx: Diversity is a hallmark of a healthy microbiome. The rationale is that accumulating evidence suggests microbiome diversity prot…
view full postMarch 14, 2024
4
-

Victoria VALPARAISO
@Orange_Atomique (Twitter)RT @GMFHx: Diversity is a hallmark of a healthy microbiome. The rationale is that accumulating evidence suggests microbiome diversity prot…
view full postMarch 14, 2024
4
-

Scott Anderson
@Psychobiotic (Twitter)RT @GMFHx: Diversity is a hallmark of a healthy microbiome. The rationale is that accumulating evidence suggests microbiome diversity prot…
view full postMarch 14, 2024
4
-

GutMicrobiota Health
@GMFHx (Twitter)Diversity is a hallmark of a healthy microbiome. The rationale is that accumulating evidence suggests microbiome diversity protects against pathogens by nutrient blocking: https://t.co/5By7pQY41s
view full postMarch 14, 2024
23
4
-

J.A. Betancourt Rodríguez
@zemblanity00 (Twitter)RT @zemblanity00: Microbiome diversity: How a diverse microbiota helps protect against pathogens by consuming a wide variety of nutrients —…
view full postMarch 12, 2024
1
-

J.A. Betancourt Rodríguez
@zemblanity00 (Twitter)Microbiome diversity: How a diverse microbiota helps protect against pathogens by consuming a wide variety of nutrients — leaving fewer nutrients available for potential pathogens .. https://t.co/DxTdKoYcuG
view full postMarch 11, 2024
1
1
-

Jie Deng
@jie_eco (Twitter)RT @ErikBakkeren: Online @ScienceMagazine co-lead with @francesspragge1! We looked at why microbiome diversity protects against pathogens.…
view full postMarch 1, 2024
80
-

Lizzy Rosser
@bcells_rosser (Twitter)RT @ErikBakkeren: Online @ScienceMagazine co-lead with @francesspragge1! We looked at why microbiome diversity protects against pathogens.…
view full postFebruary 29, 2024
80
-

katie wright
@katiewr31413491 (Twitter)RT @katiewr31413491: Microbiome diversity protects against pathogens by nutrient blocking | Science.
view full postFebruary 20, 2024
1
-

Dr Laurent Chatre
@LaurentAChatre (Twitter)RT @CNRSbiologie: #ResultatScientifique
view full postFebruary 17, 2024
6
-

Carole Donne-Goussé
@CaroleDonne (Twitter)RT @CNRSbiologie: #ResultatScientifique
view full postFebruary 17, 2024
6
-

CNRS Biologie
@CNRSbiologie (Twitter)#ResultatScientifique
view full postFebruary 17, 2024
16
6
-

Ignacio F. Alberti
@IgnacioFALBERTI (Twitter)#Microbiome diversity protects against #pathogens by nutrient blocking https://t.co/4K5AYywlMP @ScienceMagazine @ErikBakkeren, @martintjahn, @CunrathOlivier, Kevin Foster and coll. (@UniofOxford) #infectiousdisease #colonizationresistance #microbiota https://t.co/Ob9I1B9WAV
view full postFebruary 16, 2024
-

nathalie corvaia
@NathalieCorvaia (Twitter)RT @GMFHx: Microbiome diversity protects against pathogens by nutrient blocking. Find out more why: https://t.co/5By7pQY41s
view full postFebruary 15, 2024
9
-

ARYAN®
@gladeolie (Twitter)https://t.co/KVce2KpTD9
view full postFebruary 14, 2024
-

ARYAN®
@gladeolie (Twitter)RT @GMFHx: Microbiome diversity protects against pathogens by nutrient blocking. Find out more why: https://t.co/5By7pQY41s
view full postFebruary 14, 2024
9
-

Sangeetha Senthil Kumar
@Sangeebio22 (Twitter)RT @GMFHx: Microbiome diversity protects against pathogens by nutrient blocking. Find out more why: https://t.co/5By7pQY41s
view full postFebruary 13, 2024
9
-

Benjamin Gold
@BenjamminGold (Twitter)RT @GMFHx: Microbiome diversity protects against pathogens by nutrient blocking. Find out more why: https://t.co/5By7pQY41s
view full postFebruary 13, 2024
9
-

katie wright
@katiewr31413491 (Twitter)Microbiome diversity protects against pathogens by nutrient blocking | Science.
view full postFebruary 13, 2024
1
1
-

Szyzygy
@Szyzygy2 (Twitter)RT @GMFHx: Microbiome diversity protects against pathogens by nutrient blocking. Find out more why: https://t.co/5By7pQY41s
view full postFebruary 13, 2024
9
-

FeedYourFuture APD
@FelthamAshleigh (Twitter)RT @GMFHx: Microbiome diversity protects against pathogens by nutrient blocking. Find out more why: https://t.co/5By7pQY41s
view full postFebruary 13, 2024
9
-

Stackmore Satṩworth! 丰
@dvharry2020 (Twitter)RT @GMFHx: Microbiome diversity protects against pathogens by nutrient blocking. Find out more why: https://t.co/5By7pQY41s
view full postFebruary 13, 2024
9
-

GutMicrobiota Health
@GMFHx (Twitter)Microbiome diversity protects against pathogens by nutrient blocking. Find out more why: https://t.co/5By7pQY41s
view full postFebruary 13, 2024
28
9
-

Dr Dimitar Georgiev
@dimitar_dr (Twitter)Колкопо по-правилно ядем, толкова по-добре живеем - резюме на тази интересна статия. #gutmicrobiome @nmgenomix_23 Microbiome diversity protects against pathogens by nutrient blocking | Science https://t.co/pQcC3pGpy2
view full postFebruary 4, 2024
-

Yongqian-Xu
@Yong_qian_Xu (Twitter)RT @ChristianRinke: Microbiome diversity protects against pathogens by nutrient blocking
view full postJanuary 20, 2024
5
-

Yoshifumi Murakami
@Leo238umi (Twitter)Fig.
view full postJanuary 19, 2024
-

Galaxy Diagnostics
@Bartonella (Twitter)The microbiome is protective to the host through a variety of roles. New research finds that a colony collectively consumes the nutrients available to it, preventing new microbes from joining in. https://t.co/0LcvXCamw7
view full postJanuary 18, 2024
-

Emmanuel G Prestat
@ManuFrenchy (Twitter)RT @MaaT_Pharma: Dr. Joël Doré, Research director at @INRAE_France shares his perspective on a recent @ScienceMagazine publication confirm…
view full postJanuary 15, 2024
3
-

nathalie corvaia
@NathalieCorvaia (Twitter)RT @MaaT_Pharma: Dr. Joël Doré, Research director at @INRAE_France shares his perspective on a recent @ScienceMagazine publication confirm…
view full postJanuary 15, 2024
3
-

Mohamad Mohty
@Mohty_EBMT (Twitter)RT @MaaT_Pharma: Dr. Joël Doré, Research director at @INRAE_France shares his perspective on a recent @ScienceMagazine publication confirm…
view full postJanuary 15, 2024
3
-

MaaT Pharma
@MaaT_Pharma (Twitter)Dr. Joël Doré, Research director at @INRAE_France shares his perspective on a recent @ScienceMagazine publication confirming the critical role of diversity in gut microbiota to protect against infection. https://t.co/KbcpiOIZtN @dorejoel https://t.co/vMFywno2sm
view full postJanuary 15, 2024
7
3
-

thetranscendedman
@atranscendedman (Twitter)@Yash25571056 Adds up: https://t.co/7UNR1fQr5P & https://t.co/caX3lOsXbD
view full postJanuary 14, 2024
-

Fabiano Santos Guimarães
@drfabianosguima (Twitter)Um estudo recente da Universidade de Oxford mostrou que um microbioma diversificado pode ser protetor contra microrganismos causadores de doenças. https://t.co/iGH8UDhUPI
view full postJanuary 13, 2024
-

Kumar Sankaran
@BiomeSankar (Twitter)https://t.co/lRMfgIRHqH
view full postJanuary 13, 2024
-

Amira Metwaly, PhD
@Amira_Metwaly (Twitter)RT @ErikBakkeren: Online @ScienceMagazine co-lead with @francesspragge1! We looked at why microbiome diversity protects against pathogens.…
view full postJanuary 11, 2024
80
-

Galaxy Diagnostics
@Bartonella (Twitter)The microbiome is protective to the host through a variety of roles. New research finds that a colony collectively consumes the nutrients available to it, preventing new microbes from joining in. https://t.co/0LcvXCamw7
view full postJanuary 11, 2024
-

James V. Kohl
@microRNApro (Twitter)@Jeremy25888564 @RichardJJohns11 We detailed the mechanisms in our section on molecular epigenetics in this review of miRNA/RNA-mediated interference. "From Fertilization to Adult Sexual Behavior" https://t.co/6dCuuvOP1y (1996) For an update, see: https://t.co/RgxMyfhlJZ 12/15/23
view full postJanuary 8, 2024
-

Yoshifumi Murakami
@Leo238umi (Twitter)January 8, 2024
-

Yoshifumi Murakami
@Leo238umi (Twitter)Fig.
view full postJanuary 8, 2024
-

成れ果て博士
@phdeggend (Twitter)【Science】腸内細菌の多様性が富んでいることは栄養の観点で病原菌定着予防に繋がる https://t.co/4aCITHvC2S 確かに漠然と多様性の保持は重要だと考えていたが、論理的に説明した論文は初めてか・・・ 腸内細菌学の一般論として引用されるだろう
view full postJanuary 7, 2024
-

bette fruchtman
@mamatocrohns (Twitter)RT @propelacure: This study demonstrates that diverse communities of key species -- versus individual species on their own -- in the gut c…
view full postJanuary 7, 2024
6
-

Roger Pasfield
@IBDBatman (Twitter)RT @propelacure: This study demonstrates that diverse communities of key species -- versus individual species on their own -- in the gut c…
view full postJanuary 7, 2024
6
-

◍ten.jie._twilight.owl ✧☁️
@Rijie17 (Twitter)RT @ScienceMagazine: Diverse gut microbiomes protect against pathogens by blocking nutrient access, according to a new Science study. The f…
view full postJanuary 6, 2024
166
-

J C O V
@CesarVindell (Twitter)RT @ScienceMagazine: Diverse gut microbiomes protect against pathogens by blocking nutrient access, according to a new Science study. The f…
view full postJanuary 6, 2024
166
-

Gonzalo Pérez Marc
@gperezmarc (Twitter)RT @ScienceMagazine: Diverse gut microbiomes protect against pathogens by blocking nutrient access, according to a new Science study. The f…
view full postJanuary 6, 2024
166
-

Cheng Hong Sheng 庄鸿昇
@hongsheng_cheng (Twitter)RT @ScienceMagazine: Diverse gut microbiomes protect against pathogens by blocking nutrient access, according to a new Science study. The f…
view full postJanuary 6, 2024
166
-

John Muir @johnmuir@aus.social
@johnamuir (Twitter)RT @ScienceMagazine: Diverse gut microbiomes protect against pathogens by blocking nutrient access, according to a new Science study. The f…
view full postJanuary 6, 2024
166
-

Kasia Hein-Peters, M.D.
@Kasia_HP (Twitter)RT @ScienceMagazine: Diverse gut microbiomes protect against pathogens by blocking nutrient access, according to a new Science study. The f…
view full postJanuary 6, 2024
166
-

Nelson Maica C
@jupiterxc (Twitter)RT @ScienceMagazine: Diverse gut microbiomes protect against pathogens by blocking nutrient access, according to a new Science study. The f…
view full postJanuary 6, 2024
166
-

Norio Nakatsuji
@norionakatsuji (Twitter)RT @ScienceMagazine: Diverse gut microbiomes protect against pathogens by blocking nutrient access, according to a new Science study. The f…
view full postJanuary 6, 2024
166
-

Xavi Granda Revilla
@xavigranda (Twitter)RT @ScienceMagazine: Diverse gut microbiomes protect against pathogens by blocking nutrient access, according to a new Science study. The f…
view full postJanuary 6, 2024
166
-

Terrence Myles
@TerrenceMyles (Twitter)RT @ScienceMagazine: Diverse gut microbiomes protect against pathogens by blocking nutrient access, according to a new Science study. The f…
view full postJanuary 6, 2024
166
-

Brian Coombes, PhD
@BrianKCoombes (Twitter)RT @propelacure: This study demonstrates that diverse communities of key species -- versus individual species on their own -- in the gut c…
view full postJanuary 6, 2024
6
-

Shapley Fürskyn
@shiva137 (Twitter)RT @ScienceMagazine: Diverse gut microbiomes protect against pathogens by blocking nutrient access, according to a new Science study. The f…
view full postJanuary 6, 2024
166
-

Diagoras 1er
@DiagorasDeMilos (Twitter)RT @ScienceMagazine: Diverse gut microbiomes protect against pathogens by blocking nutrient access, according to a new Science study. The f…
view full postJanuary 6, 2024
166
-

RetireWell
@Tech2Meet (Twitter)RT @ScienceMagazine: Diverse gut microbiomes protect against pathogens by blocking nutrient access, according to a new Science study. The f…
view full postJanuary 6, 2024
166
-

Anthony Jones
@bagan00 (Twitter)RT @ScienceMagazine: Diverse gut microbiomes protect against pathogens by blocking nutrient access, according to a new Science study. The f…
view full postJanuary 6, 2024
166
-

R A Popalzai
@Radion_Popalzai (Twitter)RT @ScienceMagazine: Diverse gut microbiomes protect against pathogens by blocking nutrient access, according to a new Science study. The f…
view full postJanuary 6, 2024
166
-

Joana
@Jobargom6 (Twitter)RT @ScienceMagazine: Diverse gut microbiomes protect against pathogens by blocking nutrient access, according to a new Science study. The f…
view full postJanuary 6, 2024
166
-

Renzo Garcia
@renzoagarciac (Twitter)RT @ScienceMagazine: Diverse gut microbiomes protect against pathogens by blocking nutrient access, according to a new Science study. The f…
view full postJanuary 6, 2024
166
-

Ghazwan Butrous
@gbutrous (Twitter)RT @ScienceMagazine: Diverse gut microbiomes protect against pathogens by blocking nutrient access, according to a new Science study. The f…
view full postJanuary 6, 2024
166
-

Nicolas Maughan
@nicolasmaughan (Twitter)RT @ScienceMagazine: Diverse gut microbiomes protect against pathogens by blocking nutrient access, according to a new Science study. The f…
view full postJanuary 6, 2024
166
-

Abdul-Karim
@AKAMkanga (Twitter)RT @ScienceMagazine: Diverse gut microbiomes protect against pathogens by blocking nutrient access, according to a new Science study. The f…
view full postJanuary 6, 2024
166
-

delthia ricks
@DelthiaRicks (Twitter)RT @ScienceMagazine: Diverse gut microbiomes protect against pathogens by blocking nutrient access, according to a new Science study. The f…
view full postJanuary 6, 2024
166
-

Eder Andrés
@ederandres152 (Twitter)RT @ScienceMagazine: Diverse gut microbiomes protect against pathogens by blocking nutrient access, according to a new Science study. The f…
view full postJanuary 6, 2024
166
-

Prof. Dr. Hakan YALÇIN
@hakanyalcintr (Twitter)RT @ScienceMagazine: Diverse gut microbiomes protect against pathogens by blocking nutrient access, according to a new Science study. The f…
view full postJanuary 6, 2024
166
-

अनुज द्विवेदी, (अर्जुन)
@D__Arjun (Twitter)RT @ScienceMagazine: Diverse gut microbiomes protect against pathogens by blocking nutrient access, according to a new Science study. The f…
view full postJanuary 6, 2024
166
-

FJ
@FrJuHeAl (Twitter)RT @ScienceMagazine: Diverse gut microbiomes protect against pathogens by blocking nutrient access, according to a new Science study. The f…
view full postJanuary 6, 2024
166
-

Nathan
@nathanallenwade (Twitter)RT @ScienceMagazine: Diverse gut microbiomes protect against pathogens by blocking nutrient access, according to a new Science study. The f…
view full postJanuary 6, 2024
166
-

Microbiology
@X_Microbiology (Twitter)RT @propelacure: This study demonstrates that diverse communities of key species -- versus individual species on their own -- in the gut c…
view full postJanuary 6, 2024
6
-

ぜのぱす(初代_凍結から快復)
@Xenopus007 (Twitter)RT @ScienceMagazine: Diverse gut microbiomes protect against pathogens by blocking nutrient access, according to a new Science study. The f…
view full postJanuary 6, 2024
166
-

Jacob K. McPherson
@JacobKMcPherson (Twitter)RT @ScienceMagazine: Diverse gut microbiomes protect against pathogens by blocking nutrient access, according to a new Science study. The f…
view full postJanuary 6, 2024
166
-

andromeda
@astroid_belt (Twitter)RT @ScienceMagazine: Diverse gut microbiomes protect against pathogens by blocking nutrient access, according to a new Science study. The f…
view full postJanuary 6, 2024
166
-

Judy
@KarabelleMommy (Twitter)RT @propelacure: This study demonstrates that diverse communities of key species -- versus individual species on their own -- in the gut c…
view full postJanuary 6, 2024
6
-

Mark O. Martin
@markowenmartin (Twitter)RT @ScienceMagazine: Diverse gut microbiomes protect against pathogens by blocking nutrient access, according to a new Science study. The f…
view full postJanuary 6, 2024
166
-

NeuroPsiqMex
@MexPsiq (Twitter)RT @ScienceMagazine: Diverse gut microbiomes protect against pathogens by blocking nutrient access, according to a new Science study. The f…
view full postJanuary 6, 2024
166
-

Dr. Celeste Allaband
@LabAllaband (Twitter)RT @ScienceMagazine: Diverse gut microbiomes protect against pathogens by blocking nutrient access, according to a new Science study. The f…
view full postJanuary 6, 2024
166
-

CarlosAguilarSalinas
@caguilarsalinas (Twitter)RT @ScienceMagazine: Diverse gut microbiomes protect against pathogens by blocking nutrient access, according to a new Science study. The f…
view full postJanuary 6, 2024
166
-

The Colitist
@colitist (Twitter)RT @propelacure: This study demonstrates that diverse communities of key species -- versus individual species on their own -- in the gut c…
view full postJanuary 6, 2024
6
-

All India Doctors
@AllIndiaDoctors (Twitter)RT @ScienceMagazine: Diverse gut microbiomes protect against pathogens by blocking nutrient access, according to a new Science study. The f…
view full postJanuary 6, 2024
166
-

John Greene
@Greene_Thoughts (Twitter)RT @ScienceMagazine: Diverse gut microbiomes protect against pathogens by blocking nutrient access, according to a new Science study. The f…
view full postJanuary 6, 2024
166
-

yellow ochre
@_yellow_ochre (Twitter)RT @ScienceMagazine: Diverse gut microbiomes protect against pathogens by blocking nutrient access, according to a new Science study. The f…
view full postJanuary 6, 2024
166
-

⚫️ลัคกี้⚡️
@sr_wiz (Twitter)RT @ScienceMagazine: Diverse gut microbiomes protect against pathogens by blocking nutrient access, according to a new Science study. The f…
view full postJanuary 6, 2024
166
-

Astro Gio
@Astro_Gio (Twitter)RT @ScienceMagazine: Diverse gut microbiomes protect against pathogens by blocking nutrient access, according to a new Science study. The f…
view full postJanuary 6, 2024
166
-

Science Magazine
@ScienceMagazine (Twitter)Diverse gut microbiomes protect against pathogens by blocking nutrient access, according to a new Science study. The findings highlight why #microbiome diversity is important to human health.
view full postJanuary 6, 2024
477
166
-

Pandeng Wang
@PandengWang (Twitter)RT @ChristianRinke: Microbiome diversity protects against pathogens by nutrient blocking
view full postJanuary 4, 2024
5
-

Ildiko ☕️
@IldikoMe (Twitter)This paper is not IBD-specific but explains a lot about why and how the microbiome is, in my view, most relevant to IBD: by protecting against infection and modulating the immune response. Microbiome diversity protects against pathogens by nutrient blocking by Spragge et al.
view full postDecember 30, 2023
3
-

Marita Ostos
@MaritaOstos (Twitter)Microbiome diversity protects against pathogens by nutrient blocking | Science https://t.co/asrIgeX3ZI
view full postDecember 29, 2023
-

Dr. Thomas Wilckens
@Thomas_Wilckens (Twitter)Microbiome diversity protects against pathogens by nutrient blocking https://t.co/pcsStGZT3N A diverse microbiome protects you better against pathogenic species @ScienceMag
view full postDecember 27, 2023
2
-

Lalit Patil
@LalitPlant (Twitter)RT @_jake_robinson: ‘Microbiome diversity protects against pathogens by nutrient blocking’ https://t.co/tH4l35FBPK “colonization resist…
view full postDecember 24, 2023
39
-

Bala.CSK
@balahumed (Twitter)Microbiome diversity protects against pathogens by nutrient blocking | Science https://t.co/Ng3NAmxDks
view full postDecember 24, 2023
-

Todd McKenzie
@ToddEBear (Twitter)Microbiome diversity protects against pathogens by nutrient blocking | Science https://t.co/l6b7dP5s1r
view full postDecember 24, 2023
-

ELISA CINTADO REYES
@CintadoElisa (Twitter)RT @labexARBRE: ... microbiota members block pathogen growth by consuming the nutrients that the pathogen needs.....Microbiome diversity pr…
view full postDecember 23, 2023
3
-

Abraham E. Gracia R.
@Abraham_RMI (Twitter)Microbiome diversity protects against pathogens by nutrient blocking Via @ScienceMagazine CC @Lizzie_Tegui https://t.co/viehTq1BdK
view full postDecember 23, 2023
2
-

Pascal Frey @pascal-frey.bsky.social
@pascal_frey (Twitter)RT @labexARBRE: ... microbiota members block pathogen growth by consuming the nutrients that the pathogen needs.....Microbiome diversity pr…
view full postDecember 23, 2023
3
-

.
@gamonasterioo (Twitter)Intestinal microbiome diversity protects against pathogens by nutrient blocking | Science https://t.co/snZqrh4adO
view full postDecember 23, 2023
2
-

お茶柱/心理学のべレスク
@otea_stalk (Twitter)【生体外他】なぜ腸内細菌の多様性が必要なの? 肺炎桿菌と腸サルモネラに100の腸内細菌ををテスト 個別で培養しても変化はなく 50種だと、明らかに病原体の増殖効率が低下していた 無菌マウスでも確認できた 栄養素を遮断しているよう https://t.co/4IISJ5VdPG
view full postDecember 22, 2023
1
-

Francis M. Martin
@fmartin1954 (Twitter)RT @labexARBRE: ... microbiota members block pathogen growth by consuming the nutrients that the pathogen needs.....Microbiome diversity pr…
view full postDecember 22, 2023
3
-

labexARBRE moving to ARTEMIS program
@labexARBRE (Twitter)... microbiota members block pathogen growth by consuming the nutrients that the pathogen needs.....Microbiome diversity protects against pathogens by nutrient blocking | Science https://t.co/Lo9WuMjuse
view full postDecember 22, 2023
7
3
-

Antonio J Vallecillo, PhD
@Vallecillo_AJ (Twitter)Microbiome diversity protects against pathogens by nutrient blocking. https://t.co/FDJ2v585jN
view full postDecember 21, 2023
-
Animalcules
@bacteriophile (Twitter)RT @dr_alphalyrae: Microbiome diversity protects against pathogens by nutrient blocking | Science https://t.co/nsC3a8UU1V
view full postDecember 21, 2023
1
-

Fesquet didier
@didierfesquet (Twitter)Microbiome diversity protects against pathogens by nutrient blocking | Science https://t.co/Y7M6DLzK3u
view full postDecember 21, 2023
-

Jeong Woo Park
@JWPark_Vaccine (Twitter)RT @HostMicrobeLit: Microbiome diversity protects against pathogens by nutrient blocking | Science I don't think this will be surprising t…
view full postDecember 21, 2023
11
-

Atlantic AI Labs
@atlanticailabs (Twitter)Microbiome diversity protects against pathogens by nutrient blocking | Science https://t.co/lGdcxzfEdT
view full postDecember 20, 2023
-

Brendan M. Lynch
@BrendanMLynch (Twitter)Microbiome diversity protects against pathogens by nutrient blocking | Science https://t.co/JyI6Mau067 https://t.co/yQ3MtyzkCg
view full postDecember 20, 2023
-

Mauricio Sanhueza-Celsi⚡
@msanhuezacelsi (Twitter)RT @Jdabanchpena: Microbiome diversity protects against pathogens by nutrient blocking | Science https://t.co/Esm8FbGXCO
view full postDecember 19, 2023
1
-

Jeannette Dabanch
@Jdabanchpena (Twitter)Microbiome diversity protects against pathogens by nutrient blocking | Science https://t.co/Esm8FbGXCO
view full postDecember 19, 2023
3
1
-

Syaifudin M
@mhsyfdn (Twitter)Microbiome diversity protects against pathogens by nutrient blocking | Science https://t.co/pStpKwC4V9
view full postDecember 19, 2023
-

Charly Emmanuel Mam
@CharlyEmmanuel8 (Twitter)RT @HostMicrobeLit: Microbiome diversity protects against pathogens by nutrient blocking | Science I don't think this will be surprising t…
view full postDecember 19, 2023
11
-

Tinkara Tinta
@TinkaraTinta (Twitter)RT @HostMicrobeLit: Microbiome diversity protects against pathogens by nutrient blocking | Science I don't think this will be surprising t…
view full postDecember 19, 2023
11
-

Diana
@PharmphoodTM (Twitter)RT @HostMicrobeLit: Microbiome diversity protects against pathogens by nutrient blocking | Science I don't think this will be surprising t…
view full postDecember 19, 2023
11
-

Maruhen Datsch Silveira
@MaruhenSilveira (Twitter)RT @HostMicrobeLit: Microbiome diversity protects against pathogens by nutrient blocking | Science I don't think this will be surprising t…
view full postDecember 19, 2023
11
-

Saubashya Sur, PhD
@SaubashyaSur (Twitter)RT @HostMicrobeLit: Microbiome diversity protects against pathogens by nutrient blocking | Science I don't think this will be surprising t…
view full postDecember 19, 2023
11
-

Aoife M Rodgers
@rodgers_aoife (Twitter)RT @HostMicrobeLit: Microbiome diversity protects against pathogens by nutrient blocking | Science I don't think this will be surprising t…
view full postDecember 19, 2023
11
-

Guillaume Minard
@GuillameMinard (Twitter)RT @BarbaraDrigoAU: Microbiome diversity protects against pathogens by nutrient blocking | Science https://t.co/iESt6uZaoL
view full postDecember 19, 2023
5
-

Makala Moore
@MakalaMoore8 (Twitter)RT @HostMicrobeLit: Microbiome diversity protects against pathogens by nutrient blocking | Science I don't think this will be surprising t…
view full postDecember 18, 2023
11
-

Shijie (SJ) Cao
@ShijieCao (Twitter)RT @HostMicrobeLit: Microbiome diversity protects against pathogens by nutrient blocking | Science I don't think this will be surprising t…
view full postDecember 18, 2023
11
-

Dr.Pankaj Losan Sharma
@PankajdFlower (Twitter)RT @HostMicrobeLit: Microbiome diversity protects against pathogens by nutrient blocking | Science I don't think this will be surprising t…
view full postDecember 18, 2023
11
-

Host Microbe interactions
@hostmicrobelit.bsky.social (Bluesky)Microbiome diversity protects against pathogens by nutrient blocking | Science I don't think this will be surprising to anyone in the field but nice to see it demonstrated in using a combination of in vitro and in vivo gnotobiotic experiments. #microbiome #science www.science.org/doi/10.1126/...
view full postDecember 18, 2023
1
-

Abish Stephen
@abish_stephen (Twitter)RT @HostMicrobeLit: Microbiome diversity protects against pathogens by nutrient blocking | Science I don't think this will be surprising t…
view full postDecember 18, 2023
11
-

Host-Microbe Interactions
@HostMicrobeLit (Twitter)Microbiome diversity protects against pathogens by nutrient blocking | Science I don't think this will be surprising to anyone in the field but nice to see it demonstrated in using a combination of in vitro and in vivo gnotobiotic experiments. https://t.co/jPM02hTKtE
view full postDecember 18, 2023
64
11
-

MiCRop - Microbial Imprinting for Crop Resilience
@MiCRop_research (Twitter)RT @BarbaraDrigoAU: Microbiome diversity protects against pathogens by nutrient blocking | Science https://t.co/iESt6uZaoL
view full postDecember 18, 2023
5
-

Kiseok (Keith) Lee | kiseokmicro.bsky.social
@kiseokmicro (Twitter)RT @_jake_robinson: ‘Microbiome diversity protects against pathogens by nutrient blocking’ https://t.co/tH4l35FBPK “colonization resist…
view full postDecember 18, 2023
39
-

Chunxu Song 宋春旭
@Chunxu_Song (Twitter)RT @BarbaraDrigoAU: Microbiome diversity protects against pathogens by nutrient blocking | Science https://t.co/iESt6uZaoL
view full postDecember 18, 2023
5
-

Enric Frago
@EnricFrago (Twitter)RT @BarbaraDrigoAU: Microbiome diversity protects against pathogens by nutrient blocking | Science https://t.co/iESt6uZaoL
view full postDecember 18, 2023
5
-

@Env_Epi_qld
@Env_epi_Qld (Twitter)Microbiome diversity protects against pathogens by nutrient blocking | Science https://t.co/3z8puVbhjr
view full postDecember 17, 2023
-

@MicrobeBook (Twitter)RT @_jake_robinson: ‘Microbiome diversity protects against pathogens by nutrient blocking’ https://t.co/tH4l35FBPK “colonization resist…
view full postDecember 17, 2023
39
-

Jake Robinson
@_jake_robinson (Twitter)RT @_jake_robinson: ‘Microbiome diversity protects against pathogens by nutrient blocking’ https://t.co/tH4l35FBPK “colonization resist…
view full postDecember 17, 2023
39
-

Markus Riegler
@riegler_markus (Twitter)RT @BarbaraDrigoAU: Microbiome diversity protects against pathogens by nutrient blocking | Science https://t.co/iESt6uZaoL
view full postDecember 17, 2023
5
-

A/Prof Barbara Drigo
@BarbaraDrigoAU (Twitter)Microbiome diversity protects against pathogens by nutrient blocking | Science https://t.co/iESt6uZaoL
view full postDecember 17, 2023
20
5
-

Ana Lucía Rengifo G.
@NaLuRengifo (Twitter)RT @_jake_robinson: ‘Microbiome diversity protects against pathogens by nutrient blocking’ https://t.co/tH4l35FBPK “colonization resist…
view full postDecember 17, 2023
39
-

PDHAD, MCAS, PTSD and ME
@FatigueMe92484 (Twitter)Microbiome diversity protects against pathogens by nutrient blocking https://t.co/AAeQxMB4Ar
view full postDecember 17, 2023
-

Environmental Illness Community
@kimkramer2012 (Twitter)Microbiome diversity protects against pathogens by nutrient blocking https://t.co/SHDib19etP
view full postDecember 17, 2023
-

Brie M. Garcia, Ph.D (she/her)
@briemgarcia (Twitter)RT @_jake_robinson: ‘Microbiome diversity protects against pathogens by nutrient blocking’ https://t.co/tH4l35FBPK “colonization resist…
view full postDecember 17, 2023
39
-

Victoria VALPARAISO
@Orange_Atomique (Twitter)RT @ArrietaLab: Beautiful microbial ecology to understand clinical microbiology. Microbiome diversity protects against pathogens by nutrien…
view full postDecember 17, 2023
25
-

Sergey Minaev
@sminaev2015 (Twitter)RT @ArrietaLab: Beautiful microbial ecology to understand clinical microbiology. Microbiome diversity protects against pathogens by nutrien…
view full postDecember 17, 2023
25
-

Saubashya Sur, PhD
@SaubashyaSur (Twitter)RT @ChristianRinke: Microbiome diversity protects against pathogens by nutrient blocking
view full postDecember 17, 2023
5
-

Inmunoluna
@inmunoluna (Twitter)RT @ArrietaLab: Beautiful microbial ecology to understand clinical microbiology. Microbiome diversity protects against pathogens by nutrien…
view full postDecember 17, 2023
25
-

Elizabeth Gomez
@elzbthjg (Twitter)RT @_jake_robinson: ‘Microbiome diversity protects against pathogens by nutrient blocking’ https://t.co/tH4l35FBPK “colonization resist…
view full postDecember 16, 2023
39
-

Arghya Mukherjee
@nomnommicrobe (Twitter)RT @ChristianRinke: Microbiome diversity protects against pathogens by nutrient blocking
view full postDecember 16, 2023
5
-

ฤดิรักบ่หักหาย
@blaueblur (Twitter)RT @ChristianRinke: Microbiome diversity protects against pathogens by nutrient blocking
view full postDecember 16, 2023
5
-

Dr. Blake Ushijima
@VibrioSoup (Twitter)RT @_jake_robinson: ‘Microbiome diversity protects against pathogens by nutrient blocking’ https://t.co/tH4l35FBPK “colonization resist…
view full postDecember 16, 2023
39
-

Koji Yahara
@KojiYahara (Twitter)RT @hlcao: Microbiome diversity protects against pathogens by nutrient blocking | Science https://t.co/Dn9xChj2AQ
view full postDecember 16, 2023
5
-

Bayar Jaff
@JaffBayar (Twitter)RT @_jake_robinson: ‘Microbiome diversity protects against pathogens by nutrient blocking’ https://t.co/tH4l35FBPK “colonization resist…
view full postDecember 16, 2023
39
-

Findlay Munro
@FinDunMun1 (Twitter)RT @_jake_robinson: ‘Microbiome diversity protects against pathogens by nutrient blocking’ https://t.co/tH4l35FBPK “colonization resist…
view full postDecember 16, 2023
39
-

Levedis
@g_levedis (Twitter)RT @_jake_robinson: ‘Microbiome diversity protects against pathogens by nutrient blocking’ https://t.co/tH4l35FBPK “colonization resist…
view full postDecember 16, 2023
39
-

WilmanAlvarezR
@WilmanAlvarezR (Twitter)RT @ArrietaLab: Beautiful microbial ecology to understand clinical microbiology. Microbiome diversity protects against pathogens by nutrien…
view full postDecember 16, 2023
25
-

Ace Bryan Sotelo Cabal
@ace_cabal (Twitter)RT @_jake_robinson: ‘Microbiome diversity protects against pathogens by nutrient blocking’ https://t.co/tH4l35FBPK “colonization resist…
view full postDecember 16, 2023
39
-

Rostand Chamedjeu
@chamedjeu (Twitter)RT @tsiafouli: Diversity matters! Microbiome diversity protects against pathogens by nutrient blocking | Science https://t.co/OpW6SfUVOv
view full postDecember 16, 2023
2
-

Tawatchai.T
@Thongkongkaew_T (Twitter)RT @_jake_robinson: ‘Microbiome diversity protects against pathogens by nutrient blocking’ https://t.co/tH4l35FBPK “colonization resist…
view full postDecember 16, 2023
39
-

Dr. Indira Mysorekar
@MysorekarLab (Twitter)RT @ArrietaLab: Beautiful microbial ecology to understand clinical microbiology. Microbiome diversity protects against pathogens by nutrien…
view full postDecember 16, 2023
25
-

Dongheon Lee
@DongheonLee3 (Twitter)RT @_jake_robinson: ‘Microbiome diversity protects against pathogens by nutrient blocking’ https://t.co/tH4l35FBPK “colonization resist…
view full postDecember 16, 2023
39
-

Ashani Karandawela
@askk403 (Twitter)RT @_jake_robinson: ‘Microbiome diversity protects against pathogens by nutrient blocking’ https://t.co/tH4l35FBPK “colonization resist…
view full postDecember 16, 2023
39
-

Nebiyat Nigusie Woldeyohannis (PhD)
@NWoldeyohannis (Twitter)RT @_jake_robinson: ‘Microbiome diversity protects against pathogens by nutrient blocking’ https://t.co/tH4l35FBPK “colonization resist…
view full postDecember 16, 2023
39
-

Dr. Kylea Garces
@ElleWoodsOfMyco (Twitter)RT @_jake_robinson: ‘Microbiome diversity protects against pathogens by nutrient blocking’ https://t.co/tH4l35FBPK “colonization resist…
view full postDecember 16, 2023
39
-

Scott Anderson
@Psychobiotic (Twitter)RT @ArrietaLab: Beautiful microbial ecology to understand clinical microbiology. Microbiome diversity protects against pathogens by nutrien…
view full postDecember 16, 2023
25
-

Prof. Chuixiang Yi
@cyi12 (Twitter)RT @_jake_robinson: ‘Microbiome diversity protects against pathogens by nutrient blocking’ https://t.co/tH4l35FBPK “colonization resist…
view full postDecember 16, 2023
39
-

Diana
@PharmphoodTM (Twitter)RT @ktguzz: Microbiome diversity protects against pathogens by nutrient blocking https://t.co/GTYjVMNncq
view full postDecember 15, 2023
6
-

Alexandra Castillo-Ruiz
@Neuro_DrAlex (Twitter)RT @ktguzz: Microbiome diversity protects against pathogens by nutrient blocking https://t.co/GTYjVMNncq
view full postDecember 15, 2023
6
-

Scott Anderson
@Psychobiotic (Twitter)RT @ktguzz: Microbiome diversity protects against pathogens by nutrient blocking https://t.co/GTYjVMNncq
view full postDecember 15, 2023
6
-

Andrea McBeth
@DreMcBeth (Twitter)RT @ktguzz: Microbiome diversity protects against pathogens by nutrient blocking https://t.co/GTYjVMNncq
view full postDecember 15, 2023
6
-

Sagittarius
@guani_vic (Twitter)RT @ktguzz: Microbiome diversity protects against pathogens by nutrient blocking https://t.co/GTYjVMNncq
view full postDecember 15, 2023
6
-

Katie Guzzetta
@ktguzz.bsky.social (Bluesky)Microbiome diversity protects against pathogens by nutrient blocking https://doi.org/10.1126/science.adj3502
view full postDecember 15, 2023
-

Katie Guzzetta
@ktguzz (Twitter)Microbiome diversity protects against pathogens by nutrient blocking https://t.co/GTYjVMNncq
view full postDecember 15, 2023
14
6
-

micropapers
@micro_papers (Twitter)Microbiome diversity protects against pathogens by nutrient blocking https://t.co/OVdMGU9bCg
view full postDecember 14, 2023
-

Ben Sheldon
@sheldonbirds.bsky.social (Bluesky)microbiome https://www.science.org/doi/10.1126/science.adg2238 https://www.science.org/doi/epdf/10.1126/science.adj3502
view full postDecember 14, 2023
-

Sciences
@sciences.skyfleet.blue (Bluesky)Microbiome diversity protects against pathogens by nutrient blocking
view full postDecember 14, 2023
-

Sciences
@sciences.skyfleet.blue (Bluesky)Microbiome diversity protects against pathogens by nutrient blocking
view full postDecember 14, 2023
1
1
-
Innovaseq
En un reciente artículo científico de Science, experimentos en ... org/doi/10.1126/science. adj3502?url_ver=Z39.88-2003&rfr_id=ori:rid:crossref ...
view full postDecember 15, 2025
Facebook
-
JCS Complete Volume 75 No 5 | PDF | Epidermis
Science. 2023;382(6676):eadj3502. doi:10.1126/science.adj3502 (162) Boxberger M, Cenizo V, Cassir N, La Scola B. Challenges in exploring and manipulating ...
view full postDecember 15, 2025
News
-
Root Bacteria Hack Another Plant Hormone and Affec | PDF ...
infectious complications—may benefit 10.1126/science.adp5011. from vaccine ... tive, and even probiotic strains could 1126/science.adj3502. MacLennan ...
view full postDecember 15, 2025
News
-
Microbiome diversity protects against pathogens by nutrient blocking ...
Science. 15 Dec 2023. Vol 382, Issue 6676. DOI: 10.1126/science.adj3502 · PREVIOUS ARTICLE. Multifaceted SOX2-chromatin interaction underpins pluripotency ...
view full postDecember 15, 2025
News
-
Salmonella Manipulates | PDF | Salmonella | Microbiota
Science. 2023;382:eadj3502. https://doi.org/10.1126/science.adj3502 PMID: 38096285 7. Rivera-Chávez F, Zhang LF, Faber F, Lopez CA, Byndloss MX, Olsan EE ...
view full postDecember 15, 2025
News
-
Metabolic Ecology of Microbiomes Nutrient Competi | PDF ...
Science ents is fundamental for ecological success in microbial commu 382, eadj3502. https://doi.org/10.1126/science.adj3502. nities, which cements the key ...
view full postDecember 15, 2025
News
-
Probiotics For Your Microbiome: Beneficial, Bad, Or Just Pointless ...
doi:10.1126/science.adj3502. [10] Rosenberg E. Diversity of bacteria within the human gut and its contribution to the functional unity of ...
view full postMarch 7, 2025
News
-
Resistencia a la colonización: la microbiota intestinal juega un ...
... 10.1126/science.adj3502 #microbiotaintestinal #microbiota #microbioma ... org/doi/10.1126/science.adj3502. science.org. Microbiome diversity ...
view full postOctober 16, 2024
Facebook
-
איילת | דיאטנית מיקרוביום | עד היום לא ברור כיצד המיקרוביום שלנו חוסם ...
... science.org/doi/10.1126/science.adj3502 בשל סיבות אתיות ברורות המחקר נעשה בתנאי מעבדה ובעכברים ולא בבני אדם.".
view full postApril 20, 2024
Instagram
-
In Functional Medicine, we understand that fixing the gut can help ...
... your body. To achieve whole body health, we must optimize the ecosystem of the gut. DOI: 10.1126/science.adj3502".
view full postJanuary 13, 2024
Instagram
-
[Article] Microbiome diversity protects against pathogens by nutrient ...
URL: https://www.science.org/doi/10.1126/science.adj3502?utm_campaign=SciMag&utm_source=Twitter&utm_medium=ownedSocial DOI…
view full postJanuary 10, 2024
Reddit
-
Así combate las infecciones nuestra flora intestinal, según la ciencia
Ahora, un nuevo estudio publicado en la revista especializada Science ... Science (2023). DOI:10.1126/science.adj3502 · ¿Quieres recibir los ...
view full postJanuary 2, 2024
News
-
肠道定植菌“制裁”病原菌入侵“手段”大揭秘!_病原体_竞争_研究
肠道菌群是如何对抗病原菌入侵的呢?2023年12月15号一篇题为“Microbiomediversity protects against pathogens by nutrientblocking”发表在Science上 ...
view full postDecember 29, 2023
News
-
Science:多样化的肠道细菌群落通过营养阻断来抵御有害健康的病原菌
Science, 2023, doi:10.1126/science.adj3502. Study shows diverse gut bacteria communities protect against harmful pathogens by nutrient ...
view full postDecember 26, 2023
News
-
Pablo - La diversidad del microbioma protege contra patógenos ...
... science. org/doi/10.1126/science. adj3502?utm_campaign=SciMag&utm_source=Twitte r&utm_medium=ownedSocial El estudio encontró que al combinar ...
view full postDecember 20, 2023
Facebook
-
“小柯”秀----中国科学院
org/10.1126/science.adj3502. 《物理评论A》科学家实现超图态纠缠纯化德国锡根大学Lina Vandré等人实现了超图态的纠缠纯化。相关研究12月14日发表于 ...
view full postDecember 19, 2023
News
-
This may have implications for chronic illness. "Our results support ...
https://www.science. org/doi/10.1126/science.adj3502 Frances Spragge, Erik Bakkeren, Martin Jahn, Elizete Araujo, Claire Pearson, Xuedan ...
view full postDecember 19, 2023
Facebook
-
Microbiome Diversity Protects Against Pathogens by Nutrient ...
Permalink: https://www.science.org/doi/10.1126/science.adj3502. I am a bot, and this action was performed automatically. Please contact the ...
view full postDecember 18, 2023
Reddit
-
Diverse gut bacteria communities protect against harmful pathogens ...
Microbiome diversity protects against pathogens by nutrient blocking. Science, 2023; 382 (6676) DOI: 10.1126/science.adj3502. Cite This Page:.
view full postDecember 17, 2023
News
-
微生物群多样性通过阻断营养来抵御病原体—小柯机器人—科学网
DOI: adj3502. Source: https://www.science.org/doi/10.1126/science.adj3502. 期刊信息. Science:《科学》,创刊于1880年。隶属于美国科学促进会 ...
view full postDecember 16, 2023
News
-
Diverse gut microbiomes give better protection against harmful bugs ...
org/doi/10.1126/science.adj3502 #microbiome #functionalnutrition #guthealth · No photo description available ...
view full postDecember 16, 2023
Facebook
-
Protective bacterial communities consume the nutrients to starve out ...
Science. doi.org/10.1126/science.adj3502. Currently rated 5.0 by 2 people. Posted in: Medical Science News | Biochemistry | Disease/Infection ...
view full postDecember 15, 2023
Blogs
-
CONTENTS
Spragge et al. RESEARCH ARTICLE SUMMARY; FOR FULL TEXT: DOI.ORG/10.1126/SCIENCE.ADJ3502. PERSPECTIVE p. 1244. 1260 Mesoscopic physics. Emission ...
view full postDecember 15, 2023
News
-
In Science Journals | Science
Science, adj3502, this issue p. 1259; see also adl5891, p ... https://www.science.org/doi/10.1126/science.adn4662. Copy Link. Copied ...
view full postDecember 14, 2023
News
-
Diverse gut bacteria communities protect against harmful pathogens ...
... Science at 19:00 GMT/ 14:00 ET on Thursday 14 December at http://www.science.org/doi/10.1126/science.adj3502 DOI 10.1126/science.adj3502.
view full postDecember 14, 2023
News
-
Curcumin has always been one of my favorite natural supports for ...
Uric acid isn't just about gout. It's a key inflammatory marker that can impact your liver, weight, and risk of chronic disease when it's ...
view full postJuly 7, 2023
Instagram
-
'Genetically engineered gut bacterium could protect bees from ...
DOI Not Found | Science. © 2019 American Association for the ... org/doi/10.1126/science.adj3502 #microbiome #functionalnutrition #guthealth.
view full postJune 13, 2023
Facebook
-
Innovaseq - Damos la bienvenida a la Dra. Manuela Zea ...
... science. org/doi/10.1126/science. adj3502?url_ver=Z39.88-2003&rfr_id=ori:rid:crossref. org&rfr_dat=cr_pub%20%200pubmed No room at the ...
view full postFebruary 28, 2023
Facebook
-
Hoy recordamos a nuestro aliado Dr. Theo Pérez-Gerdel @drtheofit ...
... science. org/doi/10.1126/science. adj3502?url_ver=Z39.88-2003&rfr_id=ori:rid:crossref. org&rfr_dat=cr_pub%20%200pubmed No room at the ...
view full postFebruary 23, 2023
Facebook
-
Damos la bienvenida a la Dra. Ana María Betancur, Practicante de ...
... science.org/doi/10.1126/science.adj3502?url_ver=Z39.88-2003&rfr_id=ori:rid:crossref.org&rfr_dat=cr_pub%20%200pubmed No room at the table ...
view full postFebruary 16, 2023
Instagram
-
Damos la bienvenida al Dr. John Bastidas, especialista en Medicina ...
... science. org/doi/10.1126/science. adj3502?url_ver=Z39.88-2003&rfr_id=ori:rid:crossref. org&rfr_dat=cr_pub%20%200pubmed No room at the ...
view full postFebruary 16, 2023
Facebook
-
Damos la bienvenida a la Dra. Mariana Restrepo, Nutricionista ...
... science. org/doi/10.1126/science. adj3502?url_ver=Z39.88-2003&rfr_id=ori:rid:crossref. org&rfr_dat=cr_pub%20%200pubmed No room at the ...
view full postFebruary 15, 2023
Facebook
-
One of the biggest myths of the nutrition industry is the perceived ...
As they dug deeper, it turns out that these sweetener substitutes alter the gut bacteria. Sugar substitutes trigger weight gain most likely ...
view full postApril 1, 2022
Instagram
-
"Calories in, Calories out" is one of the most misleading concepts in ...
The order in which you eat the foods also affects how fast sugar is absorbed. For example, eating protein, fat, and vegetables first will ...
view full postMarch 28, 2022
Instagram
-
Taking notes from @bengreenfieldfitness and getting in a fasted ...
Uric acid isn't just about gout. It's a key inflammatory marker that can impact your liver, weight, and risk of chronic disease when it's ...
view full postAugust 22, 2021
Instagram
-
Government advice on preventative health measures
To achieve whole body health, we must optimize the ecosystem of the gut. DOI: 10.1126/science.adj3502.
view full postJuly 9, 2020
Facebook
-
#FunFact: There are trillions of organisms living INSIDE and ON our ...
To achieve whole body health, we must optimize the ecosystem of the gut. DOI: 10.1126/science.adj3502.
view full postJanuary 22, 2018
Facebook
Abstract Synopsis
- The study explains how diverse gut microbiomes protect against pathogens mainly by consuming nutrients that pathogens would otherwise use to grow.
- Single bacterial species generally don’t provide much resistance, but a diverse community significantly boosts the ability to resist colonization, especially if specific protective species are present.
- These findings help predict which microbiome compositions can fend off new pathogens, offering insights for designing beneficial microbial communities to prevent infections.]

Maria I. Limardo Ph.D, CMIQP, CEHP
@MariaLimardo (Twitter)